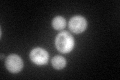
YDR487C
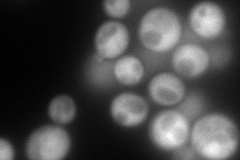
YDR487C
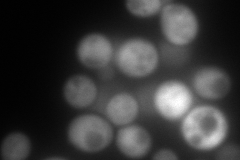
YDR487C
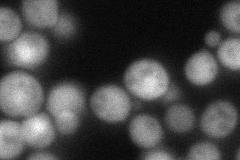
YDR487C
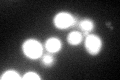
YDR487C

View description
3,4-dihydroxy-2-butanone-4-phosphate synthase (DHBP synthase), required for riboflavin biosynthesis from ribulose-5-phosphate, also has an unrelated function in mitochondrial respiration
Localization:
Intensity:
Fold change:
Significance:
-
C’ GFP library in SD
cytosol107.26 -
N' NOP1pr-GFP in SD
cytosol234.311 -
N' TEF2pr-mCherry in SD
cytosol266.672 -
N' NATIVEpr-GFP in SD
cytosol69.2313 -
N' TEF2pr-VC and Cyto-VN in SD

#N/A0 -
C’ GFP library in SD+DTT
cytosol107.61No -
C’ GFP library in SD+H2O2

cytosol72.960.68No -
C’ GFP library in Starvation Media

cytosol98.30.91No -
C’ GFP library on the background of Pup2-DaMP

cytosol -
C’ GFP library on the background of CCT mutant

cytosol95.12790.886835No
